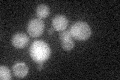
YJL187C
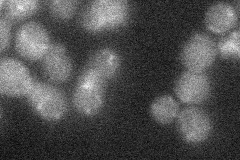
YJL187C

View description
Protein kinase that regulates the G2/M transition by inhibition of Cdc28p kinase activity; localizes to the nucleus and to the daughter side of the mother-bud neck; homolog of S. pombe Wee1p; potential Cdc28p substrate
Localization:
Intensity:
Fold change:
Significance:
-
C’ GFP library in SD
cytosol19.55 -
N' NOP1pr-GFP in SD

bud neck43.8686 -
N' TEF2pr-mCherry in SD

missing0 -
N' NATIVEpr-GFP in SD
below threshold18.6683 -
N' TEF2pr-VC and Cyto-VN in SD

below threshold22.5641 -
C’ GFP library in SD+DTT

cytosol18.150.92No -
C’ GFP library in SD+H2O2

cytosol17.850.91No -
C’ GFP library in Starvation Media

cytosol15.120.77No -
C’ GFP library on the background of Pup2-DaMP

cytosol -
C’ GFP library on the background of CCT mutant

cytosol19.40350.991916No
